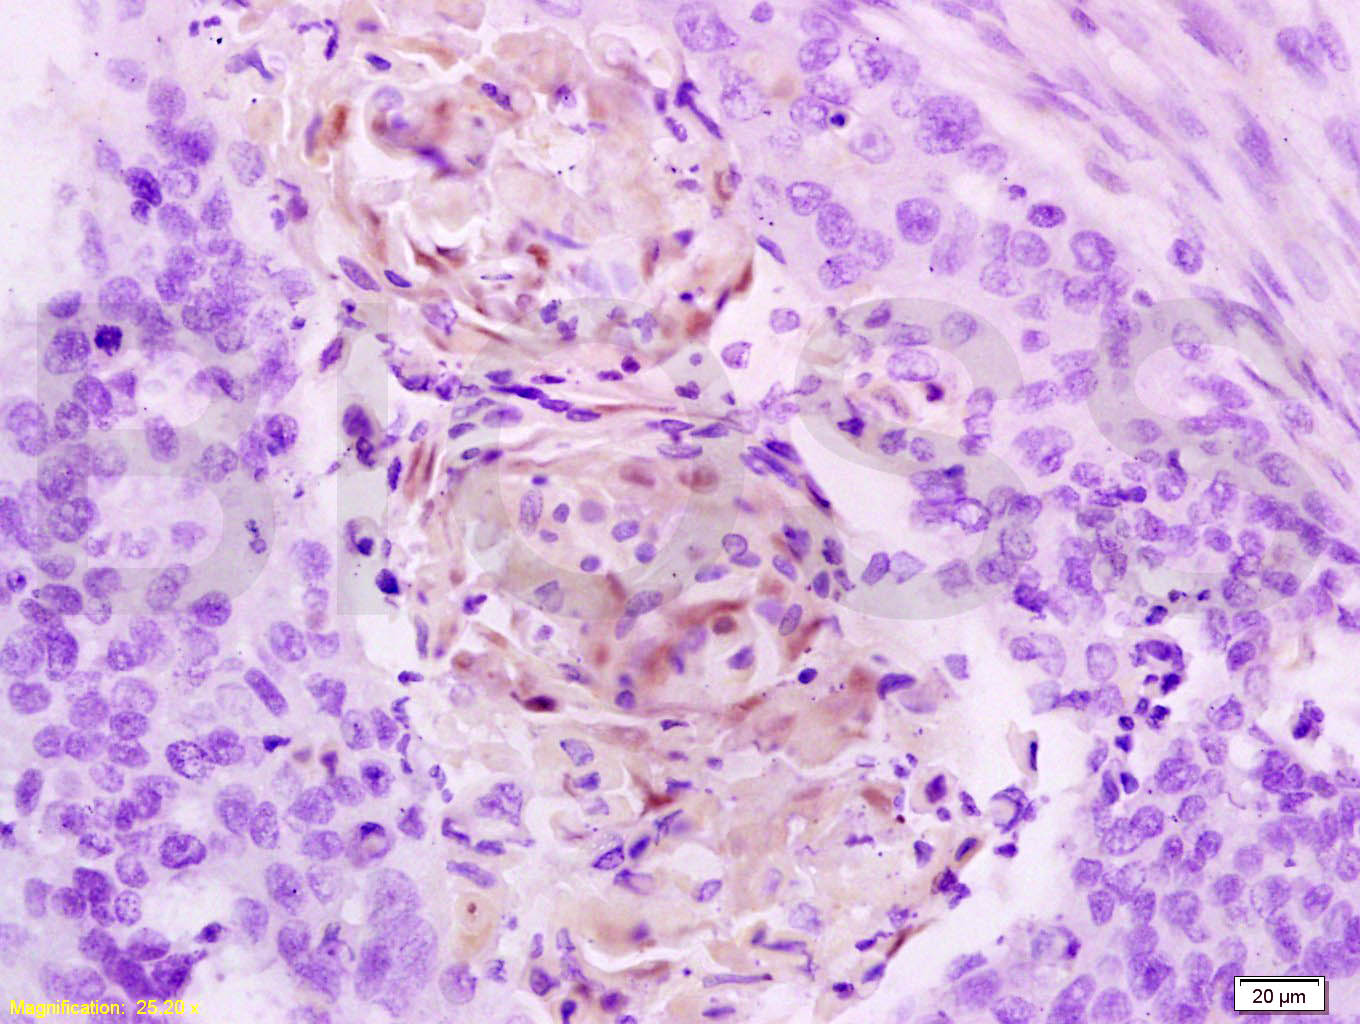
产品细节图片1

相关产品推荐更多 >
万千商家帮你免费找货
0 人在求购买到急需产品
- 详细信息
- 文献和实验
- 技术资料
- 应用范围:
产品信息以Bioss网站为准
- 规格:
50ul/100ul/200ul
| 规格: | 50ul | 产品价格: | ¥1180.0 |
|---|---|---|---|
| 规格: | 100ul | 产品价格: | ¥1980.0 |
| 规格: | 200ul | 产品价格: | ¥2800.0 |
| 产品编号 | bs-1500R |
| 英文名称 | Cathepsin B Rabbit pAb |
| 中文名称 | 组织蛋白酶B抗体 |
| 英文别名 | Amyloid precursor protein secretase; APP secretase; APPS; Cathepsin B; CB; Cathepsin B1; CathepsinB; CPSB; CTSB; Cysteine protease; Preprocathepsin B; Cathepsin B heavy chain; Cathepsin B light chain; CATB_HUMAN. |
| 产品应用 | WB=1:500-2000, IHC-P=1:100-500, IHC-F=1:100-500, IF=1:100-500, Flow-Cyt=1µg/Test Not yet tested in other applications. |
| 交叉反应 | Human, Mouse, Rat |
| 抗体来源 | Rabbit |
| 免疫原 | KLH conjugated synthetic peptide derived from human Cathepsin B heavy chain |
| 亚型 | IgG |
| 性状 | Liquid |
| 纯化方法 | affinity purified by Protein A |
| 克隆类型 | Polyclonal |
| 理论分子量 | 23/28/37 kDa |
| 浓度 | 1mg/ml |
| 储存液 | 0.01M TBS (pH7.4) with 1% BSA, 0.02% Proclin300 and 50% Glycerol. |
| 研究领域 | Cancer > Invasion/microenvironment > Angiogenesis > ECM enzymes > Cathespins Cancer > Invasion/microenvironment > ECM > Cell adhesion Cancer > Invasion/microenvironment > ECM > Extracellular matrix Kits/ Lysates/ Other > Kits > ELISA Kits > ELISA Kits > Adhesion molecules ELISA kits Neuroscience > Cell Adhesion Proteins > Membrane Proteins Signal Transduction > Cytoskeleton / ECM > Extracellular Matrix > ECM Enzymes > Other Enzymes |
| 亚基 | Dimer of a heavy chain and a light chain cross-linked by a disulfide bond. Interacts with SRPX2. |
| 亚细胞定位 | Lysosome. Melanosome. Note=Identified by mass spectrometry in melanosome fractions from stage I to stage IV. |
| 相似性 | Belongs to the peptidase C1 family. |
| 功能 | Thiol protease which is believed to participate in intracellular degradation and turnover of proteins. Has also been implicated in tumor invasion and metastasis. |
| 保存条件 | Shipped at 4℃. Store at -20℃ for one year. Avoid repeated freeze/thaw cycles. |
| 注意事项 | This product as supplied is intended for research use only, not for use in human, therapeutic or diagnostic applications. |
| 背景资料 | The protein encoded by this gene is a lysosomal cysteine proteinase composed of a dimer of disulfide-linked heavy and light chains, both produced from a single protein precursor. It is also known as amyloid precursor protein secretase and is involved in the proteolytic processing of amyloid precursor protein (APP). Incomplete proteolytic processing of APP has been suggested to be a causative factor in Alzheimer disease, the most common cause of dementia. Overexpression of the encoded protein, which is a member of the peptidase C1 family, has been associated with esophageal adenocarcinoma and other tumors. At least five transcript variants encoding the same protein have been found for this gene. [provided by RefSeq, Jul 2008] |
| 应用 | 推荐稀释比例 |
| {WB} | {1:500-2000} |
| {IHC-P} | {1:100-500} |
| {IHC-F} | {1:100-500} |
| {IF} | {1:100-500} |
| {Flow-Cyt} | {1µg/Test} |
Antigen retrieval: citrate buffer ( 0.01M, pH 6.0 ), Boiling bathing for 15min; Block endogenous peroxidase by 3% Hydrogen peroxide for 30min; Blocking buffer (normal goat serum,C-0005) at 37℃ for 20 min;
Incubation: Anti-Cathepsin B Polyclonal Antibody, Unconjugated(bs-1500R) 1:200, overnight at 4°C, followed by conjugation to the secondary antibody(SP-0023) and DAB(C-0010) staining

Spleen (Mouse) Lysate at 40 ug
Primary: Anti-Cathepsin B (bs-1500R) at 1/300 dilution
Secondary: IRDye800CW Goat Anti-Rabbit IgG at 1/20000 dilution
Predicted band size: 46/28 kD
Observed band size: 30 kD

Primary Antibody:Rabbit Anti- Cathepsin B antibody(bs-1500R), Dilution: 1μg in 100 μL 1X PBS containing 0.5% BSA;
Isotype Control Antibody: Rabbit IgG(orange) ,used under the same conditions );
Secondary Antibody: Goat anti-rabbit IgG-PE(white blue), Dilution: 1:200 in 1 X PBS containing 0.5% BSA.
Protocol
The cells were fixed with 2% Paraformaldehyde (10 min) . Antibody (bs-1500R, 5μg /1x10^6 cells) were incubated for 30 min on the ice, followed by 1 X PBS containing 0.5% BSA + 1 0% goat serum (15 min) to block non-specific protein-protein interactions. Then the Goat Anti-rabbit IgG/PE antibody was added into the blocking buffer mentioned above to react with the primary antibody of bs-1500R at 1/200 dilution for 30 min on ice. Acquisition of 20,000 events was performed.
风险提示:丁香通仅作为第三方平台,为商家信息发布提供平台空间。用户咨询产品时请注意保护个人信息及财产安全,合理判断,谨慎选购商品,商家和用户对交易行为负责。对于医疗器械类产品,请先查证核实企业经营资质和医疗器械产品注册证情况。
文献和实验[IF={{ 8.9 }}] {Wenlan Yu. et al. Long-term oral tribasic copper chloride exposure impedes cognitive function and disrupts mitochondrial metabolism by inhibiting mitophagy in rats. ENVIRON POLLUT. 2023 Nov;336:122474} {WB} {Rat}
[IF={{ 4.372 }}] {Lin Tianji. et al. Methylmercury induces lysosomal membrane permeabilization through JNK-activated Bax lysosomal translocation in neuronal cells. Toxicol Lett. 2022 Jan;:} {IF} {Human}
[IF={{ 2.438 }}] {Liru Li. et al. Rapamycin Pretreatment Alleviates Cerebral Ischemia/Reperfusion Injury in Dose-Response Manner Through Inhibition of the Autophagy and NFκB Pathways in Rats:. Dose-Response. 2020;18(3):} {WB,IF} {Rat}
[IF={{ 10.19 }}] {Xingliang Dai. et al. Crosstalk between microglia and neural stem cells influences the relapse of glioblastoma in GBM immunological microenvironment. CLIN IMMUNOL. 2023 Jun;251:109333} {IHC} {Human}
[IF={{ 0.18 }}] {Liu, B., et al. "Autophagy activation aggravates neuronal injury in the hippocampus of vascular dementia rats." Neural Regeneration Research 9.13 (2014): 1288.} {IHC} {="Rat"}
The OP9-DL1 System: Generation of T-Lymphocytes from Embryonic or Hematopoietic Stem Cells In Vitro
, and wash the strainer with OP9 medium. 54. Centrifuge the cells at 400g (1500 rpm) for 5 min at 4°C, and resuspend them in 4 mL of OP9 medium in a 15-mL tube. 55. To enrich for HSCs, add 1 mL of reconstituted rabbit
分装 F0110 干扰素-r 受体 (IFN-rR) ELISA 48T/96T 1200/2000 进口分装 F0111 抗干扰素- a 抗体 (anti-IFN- a b) ELISA 48T/96T 1200/2000 进口分装 F0112 胰岛素样生长因子-1 (IGF-1) ELISA 48T/96T 1500/2500 进口分装 F0113 胰岛素样生长因子-2 (IGF-2) ELISA 48T/96T 1500/2500
分装 F0110 干扰素-r 受体 (IFN-rR) ELISA 48T/96T 1200/2000 进口分装 F0111 抗干扰素- a 抗体 (anti-IFN- a b) ELISA 48T/96T 1200/2000 进口分装 F0112 胰岛素样生长因子-1 (IGF-1) ELISA 48T/96T 1500/2500 进口分装 F0113 胰岛素样生长因子-2 (IGF-2) ELISA 48T/96T 1500/2500
技术资料暂无技术资料 索取技术资料










